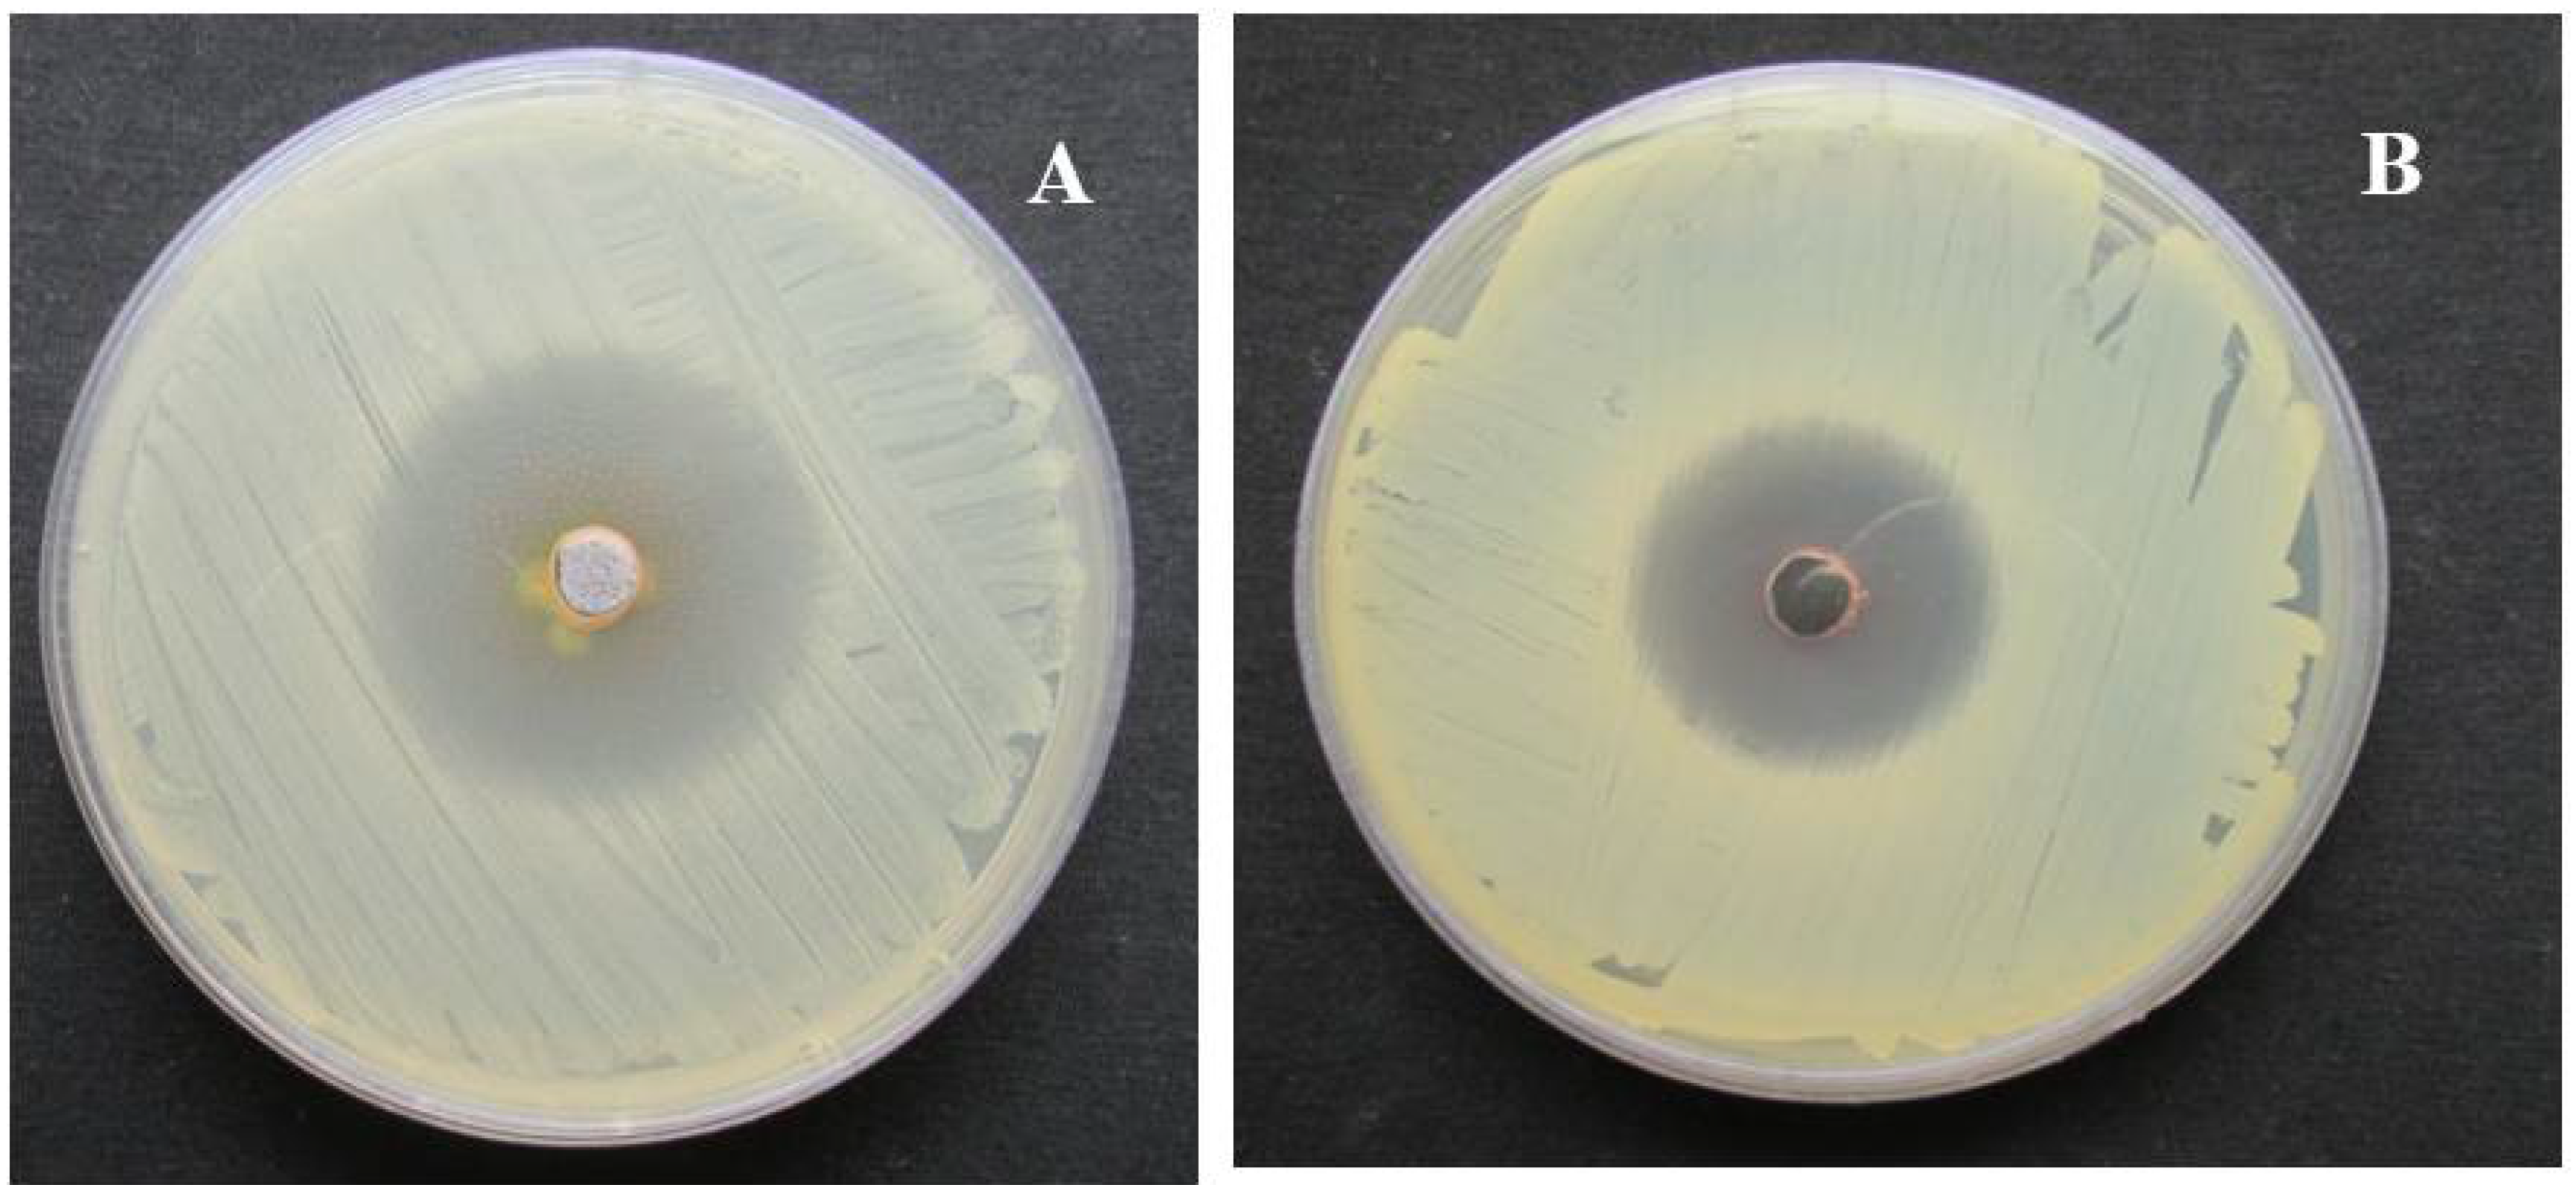
Nanomaterials 08 00279 g009 Nanomaterials 08 00279 g009

Characterization of Silver Nanomaterials Derived from Marine Streptomyces sp. Al-Dhabi-87 and Its In Vitro Application against Multidrug Resistant and Extended-Spectrum Beta-Lactamase Clinical Pathogens
Abstract
1. Introduction
2. Results
2.1. Antimicrobial Properties of the Marine Actinomycetes
2.2. Synthesis and Characterization of Silver Nanoparticles
2.3. In Vitro Antimicrobial Activity
2.3.1. Cell Suspension Inhibition Assay
2.3.2. Minimum Inhibitory Concentration (MIC) of the Nanoparticles
3. Discussion
4. Materials and Methods
4.1. Chemicals and Reagents
4.2. Isolation and Characterization of Antagonistic Actinomycetes
4.3. Synthesis and Characterization of Silver Nanoparticles
4.4. In Vitro Antimicrobial Activity
4.4.1. Microbial Pathogens
4.4.2. Cell Suspension Inhibition Assay
4.4.3. Determination of the MIC of the Nanoparticles
5. Conclusions
Author Contributions
Funding
Acknowledgments
Conflicts of Interest
References
- Belkaid, Y.; Hand, T.W. Role of the Microbiota in Immunity and inflammation. Cell 2014, 157, 121–141. [Google Scholar] [CrossRef] [PubMed]
- Francesc, R.; Ariadna, G.C.; Xavier, V.-F.; Javier, G.-L.; Miquel, B.; Jordi, V.; Angeles, M.; Yolanda, C. A bioinspired peptide scaffold with high antibiotic activity and low in vivo toxicity. Sci. Rep. 2015, 5, 10558. [Google Scholar]
- Fair Richard, J.; Yitzhak, T. Antibiotics and Bacterial Resistance in the 21st Century. Perspect. Med. Chem. 2014, 6, 25–64. [Google Scholar]
- Ullah, A.; Qasim, M.; Rahman, H.; Khan, J.; Haroon, M.; Muhammad, N.; Khan, A.; Muhammad, N. High frequency of methicillin-resistant Staphylococcus aureus in Peshawar Region of Pakistan. Springerplus 2016, 5, 600. [Google Scholar] [CrossRef] [PubMed]
- Lliah, A.; Thyagarajan, R.; Katragadda, R.; Leela, K.V.; Babu, R.N. Isolation of MRSA, ESBL and AmpC–β-lactamases from neonatal sepsis at a tertiary care hospital. J. Clin. Diagn. Res. 2014, 8, DC24. [Google Scholar]
- Lee, J.H. Methicillin (Oxacillin)-resistant Staphylococcus aureus strains isolated from major food animals and their potential transmission to humans. Appl. Environ. Microbiol. 2003, 69, 116489–116494. [Google Scholar] [CrossRef]
- Oliveira, D.C.; Milheirico, C.; Lencastre, H. Redefining a structural variant of Staphylococcal cassette chromosome mec, SCCmec type VI. Antimicrob. Agents Chemother. 2006, 50, 3457–3459. [Google Scholar] [CrossRef] [PubMed]
- Wang, L.; Hu, C.; Shao, L. The antimicrobial activity of nanoparticles: Present situation and prospects for the future. Int. J. Nanomed. 2017, 12, 1227–1249. [Google Scholar] [CrossRef] [PubMed]
- Arokiyaraj, S.; Saravanan, M.; Badathala, V. Green synthesis of Silver nanoparticles using aqueous extract of Taraxacum officinale and its antimicrobial activity. South Indian J. Biol. Sci. 2015, 2, 115–118. [Google Scholar] [CrossRef]
- Zhang, L.; Pornpattananangku, D.; Hu, C.M.; Huang, C.M. Development of nanoparticles for antimicrobial drug delivery. Curr. Med. Chem. 2010, 17, 585–594. [Google Scholar] [CrossRef] [PubMed]
- Thukral, D.K.; Dumoga, S.; Mishra, A.K. Solid lipid nanoparticles: Promising therapeutic nanocarriers for drug delivery. Curr. Drug Deliv. 2014, 11, 771–791. [Google Scholar] [CrossRef] [PubMed]
- Dizaj, S.M.; Mennati, A.; Jafari, S.; Khezri, K.; Adibkia, K. Antimicrobial activity of carbon-based nanoparticles. Adv. Pharm. Bull. 2015, 5, 19–23. [Google Scholar]
- Tiwari, P.M.; Vig, K.; Dennis, V.A.; Singh, S.R. Functionalized gold nanoparticles and their biomedical applications. Nanomaterials 2011, 1, 31–63. [Google Scholar] [CrossRef] [PubMed]
- Adibkia, K.; Javadzadeh, Y.; Dastmalchi, S.; Mohammadi, G.; Niri, F.K.; Alaei-Beirami, M. Naproxen-eudragit RS100 nanoparticles: Preparation and physicochemical characterization. Colloids Surf. B Biointerfaces 2011, 83, 155–159. [Google Scholar] [CrossRef] [PubMed]
- Buzea, C.; Pacheco, I.; Robbie, K. Nanomaterials and nanoparticles: Sources and toxicity. Biointerphases 2007, 2, MR17–MR71. [Google Scholar] [CrossRef] [PubMed]
- Shedbalkar, U.; Richa, S.; Sweety, W.; Sharvari, G.; Chopade, B.A. Microbial synthesis of gold nanoparticles: Current status and future prospects. Adv. Colloid Interface Sci. 2014, 209, 40–48. [Google Scholar] [CrossRef] [PubMed]
- Silhavy, T.J.; Kahne, D.; Walker, S. The bacterial cell envelope. Cold Spring Harb. Perspect. Biol. 2010, 2, a000414. [Google Scholar] [CrossRef] [PubMed]
- Golinska, P.; Wypij, M.; Ingle, A.P.; Gupta, I.; Dahm, H.; Rai, M. Biogenic synthesis of metal nanoparticles from actinomycetes: Biomedical applications and cytotoxicity. Appl. Microbiol. Biotechnol. 2014, 98, 8083–8097. [Google Scholar] [CrossRef] [PubMed]
- Singh, V.; Haque, S.; Singh, H.; Verma, J.; Vibha, K.; Singh, R.; Jawed, A.; Tripathi, C.K.M. Isolation, screening, and identification of novel isolates of Actinomycetes from India for antimicrobial applications. Front. Microbiol. 2016, 7, 1921. [Google Scholar] [CrossRef] [PubMed]
- Prakash, R.T.; Thiagarajan, P. Syntheses and characterization of silver nanoparticles using Penicillium sp. isolated from soil. Int. J. Adv. Sci. Res. Technol. 2012, 2, 137–149. [Google Scholar]
- Sastry, M.; Ahmad, A.; Khan, M.I.; Kumar, R. Biosynthesis of metal nanoparticles using fungi and actinomycetes. Curr. Sci. 2003, 85, 162–170. [Google Scholar]
- Deepa, S.; Kanimozhi, K.; Panneerselvam, A. Antimicrobial activity of extracellularly synthesized silver nanoparticles from marine derived actinomycetes. Int. J. Curr. Microbiol. Appl. Sci. 2013, 2, 223–230. [Google Scholar]
- Arun, P.; Shanmugaraju, V.; Renga Ramanujam, J.; Senthil Prabhu, S.; Kumaran, E. Biosynthesis of silver nanoparticles from Corynebacterium sp. and its antimicrobial activity. Int. J. Curr. Microbiol. Appl. Sci. 2013, 2, 57–64. [Google Scholar]
- Mie, R.; Samsudin, M.W.; Din, L.B.; Ahmad, A.; Ibrahim, N.; Adnan, S.N. Synthesis of silver nanoparticles with antibacterial activity using the lichen Parmotrema praesorediosum. Int. J. Nanomed. 2013, 9, 121–127. [Google Scholar] [CrossRef] [PubMed]
- Sudha, S.S.; Karthic, R.; Rengaramanujam, J. Microalgae mediated synthesis of silver nanoparticles and their antibacterial activity against pathogenic bacteria. Indian J. Exp. Biol. 2013, 51, 393–399. [Google Scholar] [PubMed]
- Natarajan, K.; Selvaraj, S.; Ramachandra Murty, V. Microbial production of silver nanoparticles. Dig. J. Nanomater. Biostruct. 2010, 5, 135–140. [Google Scholar]
- Karthik, L.; Kumar, G.; Vishnu-Kirthi, A.; Rahuman, A.A.; Rao, V.B. Streptomyces sp. LK3 mediated synthesis of silver nanoparticles and its biomedical application. Bioprocess. Biosyst. Eng. 2014, 37, 261–267. [Google Scholar] [CrossRef] [PubMed]
- Korbekandi, H.; Iravani, S.; Abbasi, S. Production of nanoparticles using organisms. Crit. Rev. Biotechnol. 2009, 29, 279–306. [Google Scholar] [CrossRef] [PubMed]
- Eppler, A.S.; Rupprechter, G.; Anderson, E.A.; Somorjai, G.A. Thermal and chemical stability and adhesion strength of Pt nanoparticle arrays supported on silica studied by transmission electron microscopy and atomic force microscopy. J. Phys. Chem. B 2000, 104, 7286–7292. [Google Scholar] [CrossRef]
- Dastjerdi, R.; Montaze, M. A review on the application of inorganic nano-structured materials in the modification of textiles: Focus on anti-microbial properties. Colloids Surf. B Biointerfaces 2010, 79, 5–18. [Google Scholar] [CrossRef] [PubMed]
- Poinern, G.E.J. A Laboratory Course in Nanoscience and Nanotechnology, 1st ed.; CRC Press/Taylor & Francis: Boca Raton, FL, USA, 2014. [Google Scholar]
- Cao, G. Nanostructures and Nanomaterials: Synthesis, Properties and Applications; Imperial College Press: London, UK, 2004. [Google Scholar]
- Feldheim, D.L.; Foss, C.A. Metal Nanoparticles: Synthesis, Characterization, and Applications; CRC Press: Boca Raton, FL, USA, 2002. [Google Scholar]
- Yao, Q.; Gao, Y.; Gao, T.; Zhang, Y.; Harnoode, C.; Dong, A.; Liu, Y.; Xiao, L. Surface arming magnetic nanoparticles with amine N-halamines as recyclable antibacterial agents: Construction and evaluation. Colloids Surf. B Biointerfaces 2016, 144, 319–326. [Google Scholar] [CrossRef] [PubMed]
- Iniyan, A.M.; Kannan, R.R.; Sharmila, J.F.J.R.; Mary Thankaraj, R.J.; Rajasekar, M.; Sumy, P.C.; Rabel, A.M.; Ramachandran, D.; Vincent, S.G.P. In vivo safety evaluation of antibacterial silver chloride nanoparticles from Streptomyces exfoliatus ICN25 in zebrafish embryos. Microb. Pathog. 2017, 112, 76–82. [Google Scholar] [CrossRef] [PubMed]
- Mukha, I.P.; Eremenko, A.M.; Smirnova, N.P.; Mikhienkova, A.I.; Korchak, G.I.; Gorchev, V.F.; Chunikhin, A.I. Antimicrobial activity of stable silver nanoparticles of a certain size. Appl. Biochem. Microbiol. 2013, 49, 199–206. [Google Scholar] [CrossRef]
- Cavassin, E.D.; de Figueiredo, L.F.P.; Otoch, J.P.; Seckler, M.M.; de Oliveira, R.A.; Franco, F.F.; Marangoni, V.S.; Zucolotto, V.; Levin, A.S.S.; Costa, S.F. Comparison of methods to detect the in vitro activity of silver nanoparticles (AgNP) against multidrug resistant bacteria. J. Nanobiotechnol. 2015, 13, 64. [Google Scholar] [CrossRef] [PubMed]
- Slavin, Y.N.; Asnis, J.; Häfeli, U.O.; Bach, H. Metal nanoparticles: Understanding the mechanisms behind antibacterial activity. J. Nanobiotechnol. 2017, 15, 65. [Google Scholar] [CrossRef] [PubMed]
- Kaviyarasu, K.; Manikandan, E.; Kennedy, J.; Maaza, M. A comparative study on the morphological features of highly ordered MgO: AgO nanocube arrays prepared via a hydrothermal method. RSC Adv. 2015, 5, 82421–82428. [Google Scholar] [CrossRef]
- Kaviyarasu, K.; Kanimozhi, K.; Matinise, N.; Maria Magdalane, C.; Genene, T.M.; Kennedy, J.; Maaza, M. Antiproliferative effects on human lung cell lines A549 activity of cadmium selenide nanoparticles extracted from cytotoxic effects: Investigation of bio-electronic application. Mater. Sci. Eng. C 2017, 76, 1012–1025. [Google Scholar] [CrossRef] [PubMed]
- Jayaprakash, N.; Judith Vijaya, J.; Kaviyarasu, K.; Kombaiah, K.; John Kennedy, L.; Jothi Ramalingam, R.; Munusamy, M.A.; Al-Lohedan, H.A. Green synthesis of Ag nanoparticles using Tamarind fruit extract for the antibacterial studies. J. Photochem. Photobiol. B Biol. 2017, 169, 178–185. [Google Scholar] [CrossRef] [PubMed]
- Anand, K.; Kaviyarasu, K.; Muniyasamy, S.; Mohana Roopan, S.; Gengan, R.M.; Chuturgoon, A.A. Bio-Synthesis of Silver nanoparticles using agroforestry residue and their catalytic degradation for sustainable waste management. J. Clust. Sci. 2017, 28, 2279–2291. [Google Scholar] [CrossRef]
- Kaviyarasu, K.; Geetha, N.; Kanimozhi, K.; Maria Magdalane, C.; Sivaranjani, S.; Ayeshamariam, A.; Kennedy, J.; Maaza, M. In vitro cytotoxicity effect and antibacterial performance of human lung epithelial cells A549 activity of zinc oxide doped TiO2 nanocrystals: Investigation of bio-medical applications. Mater. Sci. Eng. C 2017, 74, 325–333. [Google Scholar] [CrossRef] [PubMed]

| Pathogens | MIC Values (mg/mL) |
|---|---|
| Gram positive | |
| Bacillus subtilis | 1.25 |
| Enterococcus faecalis (ATCC 29212) | 0.039 |
| Staphylococcus epidermidis (ATCC 12228) | 1.25 |
| Staphylococcus aureus (ATCC 29213) | 0.039 |
| Gram negative | |
| Pseudomonas aeruginosa (ATCC 27853) | 0.039 |
| Klebsiella pneumoniae (ATCC 0063) | 0.078 |
| Escherichia coli (ATCC 25922) | 0.152 |
| Drug resistant strains | |
| Escherichia coli (ESBL 4345) | 0.018 |
| Acinetobacter baumannii (MDR 4414) | 0.039 |
| Pseudomonsa aeroginosa (MDR 4406) | 0.039 |
| Acinetobacter baumannii (MDR 4474) | 1.25 |
| Proteus mirabilis (DR 4753) | 0.018 |
| Acinetobacter baumannii (4414) | 0.312 |
| Acinetobacter baumannii (MDR 4273) | 0.156 |
| Acinetobacter baumannii (MDR 7077) | 0.312 |
| Acinetobacter baumannii (MRO 3964) | 0.018 |
| Enterococcus faecium (VRETC 773) | 0.312 |
| Enterococcus faecium (VRE UR 83198)) | 0.312 |
| Multidrug Resistant Staphylococcus aureus (WC 25 V 880854) | 0.039 |
| Multidrug Resistant Staphylococcus aureus (V 552) | 0.039 |
| Staphylococcus aureus (ATCC 43300) | 0.039 |
| Staphylococcus aureus (TC 7692) | 0.039 |
| Escherichia coli (ATCC 35218) | 0.076 |
© 2018 by the authors. Licensee MDPI, Basel, Switzerland. This article is an open access article distributed under the terms and conditions of the Creative Commons Attribution (CC BY) license (http://creativecommons.org/licenses/by/4.0/).
Share and Cite
Al-Dhabi, N.A.; Mohammed Ghilan, A.-K.; Arasu, M.V. Characterization of Silver Nanomaterials Derived from Marine Streptomyces sp. Al-Dhabi-87 and Its In Vitro Application against Multidrug Resistant and Extended-Spectrum Beta-Lactamase Clinical Pathogens. Nanomaterials 2018, 8, 279. https://doi.org/10.3390/nano8050279
Al-Dhabi NA, Mohammed Ghilan A-K, Arasu MV. Characterization of Silver Nanomaterials Derived from Marine Streptomyces sp. Al-Dhabi-87 and Its In Vitro Application against Multidrug Resistant and Extended-Spectrum Beta-Lactamase Clinical Pathogens. Nanomaterials. 2018; 8(5):279. https://doi.org/10.3390/nano8050279
Chicago/Turabian StyleAl-Dhabi, Naif Abdullah, Abdul-Kareem Mohammed Ghilan, and Mariadhas Valan Arasu. 2018. "Characterization of Silver Nanomaterials Derived from Marine Streptomyces sp. Al-Dhabi-87 and Its In Vitro Application against Multidrug Resistant and Extended-Spectrum Beta-Lactamase Clinical Pathogens" Nanomaterials 8, no. 5: 279. https://doi.org/10.3390/nano8050279
APA StyleAl-Dhabi, N. A., Mohammed Ghilan, A.-K., & Arasu, M. V. (2018). Characterization of Silver Nanomaterials Derived from Marine Streptomyces sp. Al-Dhabi-87 and Its In Vitro Application against Multidrug Resistant and Extended-Spectrum Beta-Lactamase Clinical Pathogens. Nanomaterials, 8(5), 279. https://doi.org/10.3390/nano8050279
